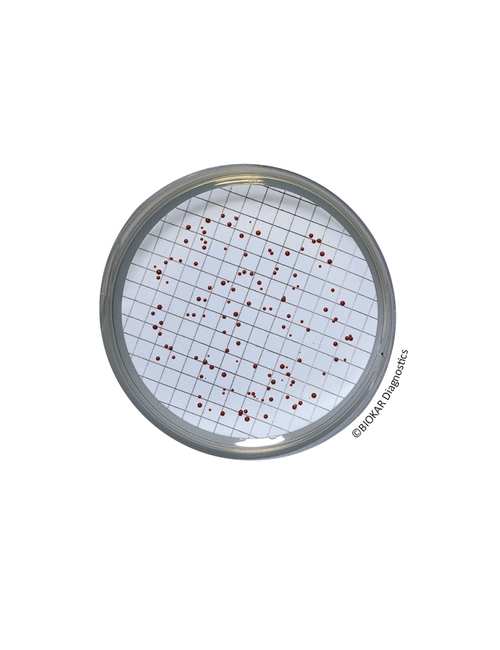
img

Slanetz and Bartley Agar
Slanetz and Bartley Agar
Slanetz ve Bartley Agar, membran filtrasyon yöntemiyle içme suyu, içecek, atık su, yüzme havuzu suyu ve hayvansal kaynaklı çeşitli biyolojik ürünlerdeki bağırsak enterokoklarının sayımı için kullanılan seçici bir besiyeridir.

Ürün Adı: Slanetz and Bartley Agar
Ürün Kodu: BS02708
Miktar: 10 şişe x 500 mL

Ürün Adı: Slanetz and Bartley Agar (without TTC)
Ürün Kodu: BK129HA
Miktar: 500 g

Ürün Adı: Slanetz and Bartley Agar
Ürün Kodu: BK037HA
Miktar: 500 g
Ürün Adı: Slanetz and Bartley Agar
Ürün Kodu: BM14608
Miktar: 20 Petri plates Ø 55 mm

Ürün Adı: Slanetz and Bartley Agar
Ürün Kodu: BM09408
Miktar: 120 Petri plates Ø 55 mm
